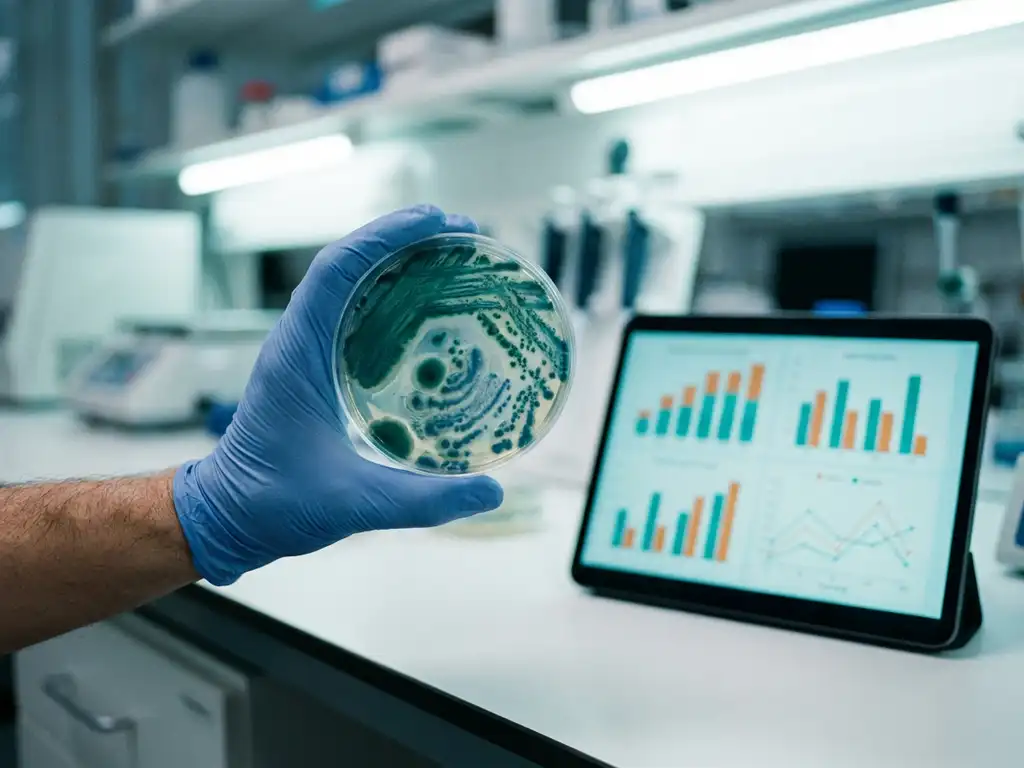
Laboratory petri dish with teal-green bacterial colonies on white bench beside tablet displaying data charts

Gut microbiome tests measure various biomarkers that reveal the health and function of your digestive ecosystem. These tests analyse bacterial diversity, metabolic outputs, inflammatory markers, and pathogen levels to provide insights into digestive function, immune health, and overall wellness. Understanding these biomarkers helps researchers and clinicians assess gut health and develop targeted interventions.
What are gut microbiome biomarkers and why do they matter?
Gut microbiome biomarkers are measurable biological indicators that reflect the composition, activity, and health of the microbial community in your digestive tract. These markers include bacterial species counts, metabolic products, immune responses, and inflammatory signals that collectively paint a picture of gut ecosystem function.
These biomarkers matter because they provide objective measurements of digestive health that extend far beyond basic symptoms. The gut microbiome influences immune function, nutrient absorption, and even systemic health through the gut–brain axis. By measuring specific biomarkers, researchers can identify imbalances, track treatment responses, and predict how interventions might affect individual patients.
Modern gut microbiome analysis relies on advanced sequencing technologies and metabolomic profiling to capture the complex interactions within the digestive ecosystem. This comprehensive approach enables precision medicine strategies and personalised treatment protocols based on individual microbiome profiles.
Which bacterial diversity markers do microbiome tests measure?
Bacterial diversity markers include alpha diversity (species richness within a sample), beta diversity (differences between samples), and species evenness measurements. Alpha diversity indicates how many different bacterial species are present, whilst beta diversity compares microbial communities between individuals or time points.
Alpha diversity metrics such as the Shannon index and Simpson’s diversity index provide insights into ecosystem stability and resilience. Higher diversity typically correlates with better digestive health and immune function. Species richness counts the total number of different bacterial species present, whilst evenness measures how uniformly distributed these species are within the community.
Beta diversity analysis reveals how similar or different microbiome compositions are between samples. This measurement helps identify distinct microbial patterns associated with health conditions, dietary interventions, or treatment responses. Understanding these diversity patterns enables researchers to stratify populations and identify responder versus non-responder profiles for targeted interventions.
What do metabolic biomarkers reveal about your gut function?
Key metabolic biomarkers include short-chain fatty acids (SCFAs) such as acetate, propionate, and butyrate, which serve as energy sources for colonocytes and help regulate gut homeostasis. These metabolites have systemic effects beyond the digestive tract, influencing immune function and metabolic health throughout the body.
SCFAs are produced when beneficial bacteria ferment dietary fibres and resistant starches. Butyrate, in particular, supports gut barrier integrity and has anti-inflammatory properties. Propionate influences glucose metabolism and satiety signalling, whilst acetate affects lipid metabolism and appetite regulation.
Other important metabolic markers include bile acids, which influence fat digestion and microbial composition, and various organic acids that reflect specific bacterial metabolic pathways. Advanced testing can differentiate substrate-specific effects, such as identifying which dietary components preferentially boost propionate versus butyrate production, enabling targeted nutritional interventions.
How do inflammatory markers in gut microbiome tests work?
Inflammatory biomarkers such as calprotectin, lactoferrin, and cytokines indicate gut barrier function and levels of intestinal inflammation. These markers reflect the immune system’s response to microbial imbalances, pathogenic bacteria, or compromised intestinal permeability.
Calprotectin is a protein released by neutrophils during inflammatory responses and serves as a sensitive marker of intestinal inflammation. Elevated levels often indicate conditions such as inflammatory bowel disease or intestinal infections. Lactoferrin, an iron-binding protein, similarly reflects inflammatory activity and immune activation within the gut.
Cytokine measurements reveal specific immune pathways activated in response to microbial changes. Pro-inflammatory cytokines such as TNF-α indicate tissue damage and immune activation, whilst anti-inflammatory markers suggest protective responses. These measurements help assess gut barrier integrity and identify individuals at risk of inflammatory digestive conditions.
What do pathogen detection markers tell you about gut health?
Pathogen detection markers identify harmful bacteria, parasites, and opportunistic pathogens that can disrupt normal digestive function. These measurements assess pathogen load and determine the clinical significance of potentially harmful microorganisms within the gut ecosystem.
Common pathogenic markers include Clostridioides difficile, pathogenic Escherichia coli strains, Salmonella species, and parasites such as Giardia or Cryptosporidium. Testing also identifies opportunistic pathogens such as Candida species that may overgrow when beneficial bacteria are depleted.
Pathogen load measurements consider both the presence and abundance of harmful organisms. Low levels of certain bacteria may be normal, whilst high concentrations indicate active infections requiring treatment. Advanced testing can distinguish between pathogenic and commensal strains of the same bacterial species, providing more precise clinical guidance for treatment decisions.
How Cryptobiotix helps with gut microbiome biomarker research
Our SIFR® technology provides comprehensive biomarker analysis for preclinical research through validated ex vivo gut simulation that maintains the original donor microbiome characteristics. This approach enables researchers to measure bacterial populations, metabolic outputs, and host–microbiome interactions, providing predictive insights into clinical outcomes.
Key capabilities include:
- Multi-omics analysis combining taxonomic profiling with metabolomic measurements
- SCFA quantification with differentiation of substrate-specific effects
- Gas production measurement as a tolerability biomarker
- Integration with human cell models for gut barrier integrity assessment
- High-throughput processing enabling interindividual variation studies
Our validated platform bridges the gap between preclinical data and clinical outcomes, addressing the “Valley of Death” in microbiome research. The technology supports regulatory submissions through mechanistic evidence generation and enables personalised intervention strategies through responder identification. Contact us to discuss how SIFR® technology can advance your gut microbiome biomarker research and accelerate product development timelines.
Frequently Asked Questions
How long does it typically take to see changes in gut microbiome biomarkers after starting an intervention?
Most gut microbiome biomarkers begin showing measurable changes within 2-4 weeks of dietary or probiotic interventions, though the timeline varies by marker type. Metabolic biomarkers like SCFAs can shift within days, whilst bacterial diversity changes typically require 4-8 weeks to stabilise. Inflammatory markers may take longer to normalise, often requiring 6-12 weeks of consistent intervention.
Can gut microbiome biomarkers predict treatment success before starting therapy?
Yes, baseline biomarker profiles can help predict treatment responses through responder identification. Specific bacterial ratios, diversity indices, and metabolic capacity markers often indicate which individuals are likely to benefit from particular interventions. This personalised approach improves treatment success rates and reduces trial-and-error approaches in clinical practice.
What factors can cause temporary fluctuations in gut microbiome biomarkers?
Recent antibiotic use, acute illness, stress, travel, and significant dietary changes can cause temporary biomarker fluctuations lasting 1-4 weeks. Menstrual cycles, sleep disruption, and exercise intensity also influence readings. For accurate baseline measurements, avoid testing during these periods or note them when interpreting results.
How do I interpret conflicting results between different types of biomarkers?
Conflicting biomarker results often reflect the dynamic nature of gut health and different measurement timeframes. For example, you might have good bacterial diversity but elevated inflammatory markers, indicating recent disruption with maintained microbial resilience. Consider the clinical context, symptom patterns, and consult with healthcare providers to prioritise which biomarkers require immediate attention.
Are there specific biomarker thresholds that indicate when professional medical intervention is needed?
Severely elevated inflammatory markers (calprotectin >250 μg/g), extremely low diversity indices, or detection of high-level pathogenic bacteria typically warrant medical evaluation. However, biomarker interpretation should always consider individual baselines, symptoms, and clinical context rather than relying solely on reference ranges. Healthcare providers can best assess when biomarker patterns indicate underlying conditions requiring treatment.